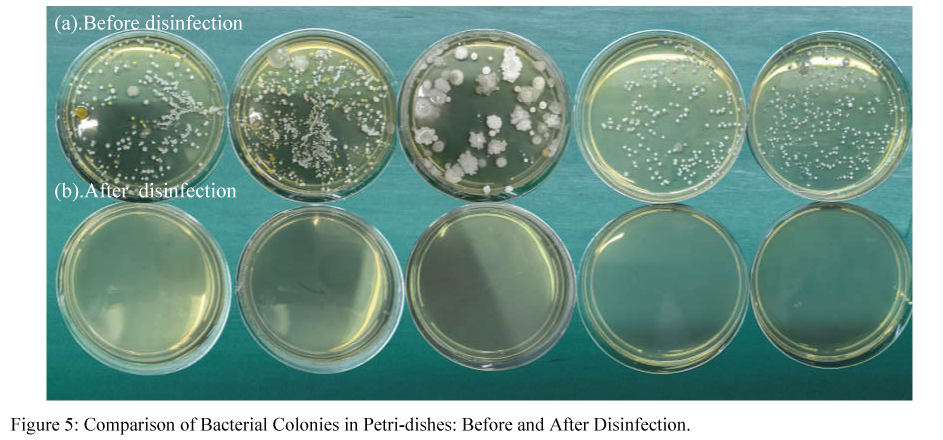
1-05

Application of UVC-LED technology in surface disinfection cabinets for small medical devices
Main text
Figures
Tables
References
The spread of infectious diseases within hospitals is notably exacerbated by cross-contamination through small medical devices such as mobile phones, blood pressure monitors, and glucose meters. However, current disinfection equipment has significant limitations: it is not only difficult to adapt to medical devices of various sizes, but also incapable of subjecting delicate electronic equipment to high-temperature disinfection processes. This situation severely hampers the effective implementation of infection prevention and control measures in hospitals. This study addresses the aforementioned challenges by designing a surface disinfection cabinet for small medical devices, utilizing UV-C LED technology as its core component. Through simulation modeling and practical testing, the disinfection efficacy of this technology on devices such as mobile phones, PDAs, and blood pressure monitors was evaluated. Collected three mobile phones, one tablet, two device remotes, and one packaging box from laboratory personnel, totaling seven small items of different materials and specifications. The colony counts before and after using the device were collected and tested, with each test repeated more than three times. The results indicate a significant reduction in the number of bacterial colonies on the sample surfaces before and after disinfection, with an average sterilization rate of 99.4%. The growth of natural bacteria in the culture dishes was less than 1 CFU/cm², meeting the requirement of a reduction in natural bacterial count by more than 1.00 log as stipulated by GB27952-2020 "General Requirements for Disinfectants on Common Object Surfaces". Additionally, tests confirmed that the device does not produce ozone and poses no risk of ultraviolet leakage in the laboratory within the factory premises, allowing for continuous use in rooms with people present.
The UV-light emitting diode (LED) has been attracting significant attention as a new UV source that can replace conventional mercury gas-filled lamps in water disinfection applications[1]. The UV spectrum is divided into three regions based on wavelength and energy: UV-A region (315-400 nm), UV-B region (280-315 nm), and UV-C region (100-280 nm). The UVC light exhibits germicidal effects and is widely used for water, surface, and air disinfection. As for UV-C LED, the emitted UVC light in the 270-280 nm range destroys the molecular structure of DNA or RNA in microbial cells by forming dimers of pyrimidines (especially thymine/uracil), leading to the death of growing and/or regenerative cells, thereby achieving sterilization [2,3]. Recent studies have also demonstrated the effectiveness of ultraviolet light in disinfection. For example, UV-C LED effectively reduces E.coli, S.aureus and C.albicans by 5 log10 units, and achieves a reduction of 3 log10 units for Bacillus cereus spores[4].
The development of disinfection devices using UVC (ultraviolet-C) light as a technology for surface disinfection in contact environments has been a focus of research for many study group[5,6]. Disinfection cabinets are widely used in hospitals to sterilize the surfaces of frequently touched electronic devices, such as tablets, mobile phones, and handheld computers. These devices may carry harmful pathogens, and susceptible patients could become infected through direct contact with these contaminated small medical diagnostic devices[7,8]. Traditionally, these cabinets have relied on mercury-based UV lamps as the primary disinfection source. While effective, mercury lamps present several challenges, including high energy consumption, long preheating times, short lifespans, and environmental concerns due to the toxic nature of mercury. Additionally, their bulky design limits integration into compact and portable sterilization systems. In contrast, UV-C LED offer a promising alternative, providing instant-on functionality, energy efficiency, longer operational lifespans, and a mercury-free, environmentally friendly solution. Their compact size allows for greater design flexibility, enabling more efficient and uniform UV-C light distribution within sterilization cabinets[9]. UV-C LED technology, compared to traditional chemical reagents, offers a non-contact disinfection method for small medical devices, making it suitable for hard-to-reach areas and leaving no residue. It addresses the limitations of high-temperature moist heat sterilization, which is not applicable to electronic products, thereby filling a gap in contemporary medical sterilization methods. This technology serves as a valuable supplement and enhancement to existing practices, providing new solutions for improving the hygiene standards of medical devices.
As advancements in UV-C LED technology continue to enhance output power and cost-effectiveness, these devices have the potential to revolutionize hospital sterilization protocols, improving disinfection efficiency while addressing safety and sustainability concerns.

2.2.1. Sampling
(1) Attach labels to the experimental items collected from the laboratory (such as iPads, mobile phones, etc.).
(2) Before disinfection, immerse a sterile cotton swab in a test tube with 5.0 mL of PBS. Swab the designated area (moving back and forth three times horizontally and vertically), then place the swab into the original PBS tube using aseptic techniques. (If the surface area is less than 50 cm², sample the entire surface; If the surface area is greater than 50 cm², sample 50 cm²).
(3) Mix the sample using a vortex mixer for 20 seconds or shake vigorously 80 times. After appropriate dilution, pipette 200 μL onto a culture medium and incubate at 36°C ± 1°C for 48 hours for viable bacterial colony counting.
2.2.2. Calculation of Total Bacterial Colony Count on Object Surfaces (see formula below):
Total Bacterial Colony Count (CFU/c㎡)=average number of colonies per plate × dilution factor ÷ sampling area (c㎡)
3.1 Sterilization rate
In this study, as shown in Figure 2, we present the design and optical simulation of a UV-C LED based disinfecting cabinet tailored for hospital use, aimed at sterilizing multiple handheld devices such as tablets. The cabinet employs an array of UV-C LEDs emitting at 275 nm, strategically placed along the top and bottom corners to optimize irradiance distribution. The interior is lined with a high-reflectivity material (reflectance >90%) to enhance light scattering and minimize absorption losses. Optical simulations, conducted using ray-tracing software, modeled the illumination of 16 surfaces across eight tablets positioned within the cabinet. Results demonstrate uniform coverage, with all surfaces receiving a UV intensity exceeding 40 µW/cm²—well above the threshold required to eliminate bacteria like Staphylococcus aureus (typically 10–20 µW/cm² for a 4 log reduction). The combination of precise LED placement and a reflective interior ensures effective disinfection, offering a compact, energy-efficient solution for infection control in clinical settings.

Figure 2. Optical Simulation of Surface Disinfection Cabinets. (a) 3D view; (b) side view and (c) UV power density distribution.
Table 3 shows the results of the ultraviolet (UV) leakage measurement. The device was placed in a laboratory, and after operating it for 5 minutes, a UV irradiance meter was used to measure the UV intensity at a distance of 30 cm around the device. The measurement was repeated three times, and the average value obtained was 0.000 μW/cm². This data effectively indicates that the surface disinfection cabinet poses no risk of UV leakage.
Table 3. UV leakage measurement.

Table 4 shows the results of the ozone leakage measurement. The device was placed in a laboratory, and after powering it on, an ozone tester was used to measure the ozone concentration in the air. It is important to note that the sampling tube of the ozone meter should be positioned at a height of 1.5 meters above the ground for accurate sampling. Measurements were taken every five minutes, and the average ozone concentration over a continuous period of one hour was 0.000 mg/cm³. This indicates that the device does not produce ozone.



Studies have shown that the hands of healthcare workers are a significant vector for the transmission of hospital-acquired pathogens. Strict adherence to hand hygiene can effectively reduce hospital-acquired infections by 20% to 30%[10]. Mobile phones, PDAs, and tablets, as frequent touched items in the daily work of healthcare workers, pose a risk of hospital-acquired infections through contact with contaminated devices. The MASSHPOTON’s surface disinfection cabinet utilizes UV-C LED lamps emitting 270-280nm ultraviolet light to disinfect small items. Items placed inside the cabinet are exposed directly and through reflective film to UV-C light, achieving disinfection without the need for direct contact with the surfaces, effectively addressing the challenge of disinfecting hard-to-reach areas on object surfaces, while eliminating concerns about chemical residues. Compared to traditional mercury lamp sterilization cabinets, the MASSHPOTON’s surface disinfection cabinet features a shorter preheating time, contributing to a more environmentally friendly system. Disinfection cabinets employing UV-C LED technology not only offer environmental benefits but also boast compact size, intelligent features, no ozone emissions, and no ultraviolet light leakage. These cabinets can rapidly reduce bacterial counts on item surfaces to 0 CFU/cm2. This innovative solution provides an effective supplementary disinfection method to chemical agents for contact surfaces in hospitals and other public spaces.
[1] Chen, J., S. Loeb and J. Kim, LED revolution: fundamentals and prospects for UV disinfection applications. Environmental science: Water research & technology, 2017. 3(2): p. 188-202.
[2] Bhardwaj SK, S.H.D.A., UVC-based photoinactivation as an efficient tool to control the transmission of coronaviruses. Sci Total Environ. 2021 Oct 2020;792:148548.
[3] Dai, T., et al., Ultraviolet C irradiation: an alternative antimicrobial approach to localized infections?. Expert review of anti-infective therapy, 2012. 10(2): p. 185-195.
[4] Helena Duering, T.W.F.K., Short-Wave Ultraviolet-Light-Based Disinfection of Surface Environment Using Light-Emitting Diodes: A New Approach to Prevent Health-Care-Associated Infections. Microorganisms, 2023(11(2), 386).
[5] Santos, T.D. and L.F. De Castro, Santos, T.D., de Castro, L.F. Evaluation of a portable Ultraviolet C (UV-C) device for hospital surface decontamination. 2021 Mar;33:102161.
[6] Corrêa, T.Q., et al., Manual Operated Ultraviolet Surface Decontamination for Healthcare Environments. 2017, Photomed. Laser Surg. 2017 Dec;35(12):666-671.
[7] Donskey, C.J., Preventing Transmission of Clostridium difficile: Is the Answer Blowing in the Wind?. Clinical infectious diseases, 2010. 50(11): p. 1458-1486.
[8] Brooks SE, V.R.K.M., Reduction in the incidence of Clostridium difficile-associated diarrhea in an acute care hospital and a skilled nursing facility following replacement of electronic thermometers with single-use disposables. 1992.Feb;13(2):98-103.
[9] Chen, J., S. Loeb and J. Kim, LED revolution: fundamentals and prospects for UV disinfection applications. Environmental science: Water research & technology, 2017. 3(2): p. 188-202.
[10] Koscova J, H.Z.P.J., Degree of bacterial contamination of mobile phone and computer keyboard surfaces and efficacy of disinfection with chlorhexidine digluconate and triclosan to its reduction. 2018.Oct 12;15(10):2238.

Get in Touch
Recent Posts
-
 MASSPHOTON will participate in WATERTECH CHINA 2026 (June 9–11, Shanghai), showcasing advanced UVC LED water disinfection modules for residential, commercial, and industrial applications. With 5-log (99.999%) disinfection performance, mercury-free operation, and high integration flexibility, the solutions support sustainable and smart water treatment. Visitors are invited to explore innovations at Booth 2.1H-413.
MASSPHOTON will participate in WATERTECH CHINA 2026 (June 9–11, Shanghai), showcasing advanced UVC LED water disinfection modules for residential, commercial, and industrial applications. With 5-log (99.999%) disinfection performance, mercury-free operation, and high integration flexibility, the solutions support sustainable and smart water treatment. Visitors are invited to explore innovations at Booth 2.1H-413. -
 This study examines how temperature influences UV-C LED performance and water disinfection efficiency. Higher temperatures reduce output power, accelerate degradation, and lead to insufficient disinfection dose. Effective thermal management is essential to ensure stable performance and reliable sterilization.
This study examines how temperature influences UV-C LED performance and water disinfection efficiency. Higher temperatures reduce output power, accelerate degradation, and lead to insufficient disinfection dose. Effective thermal management is essential to ensure stable performance and reliable sterilization.








